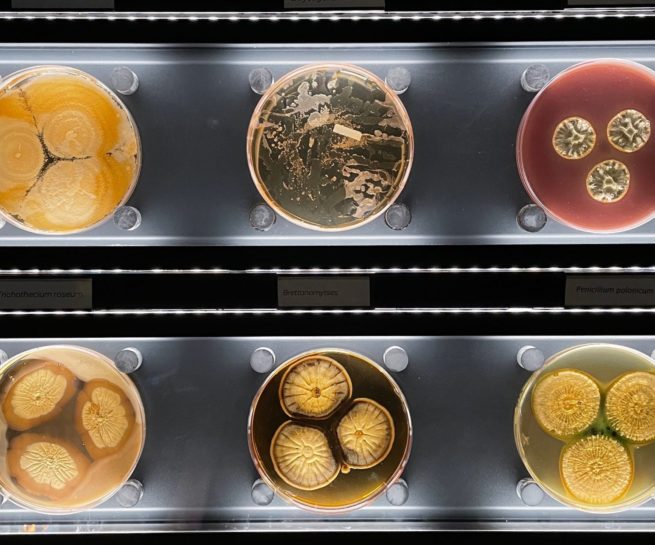
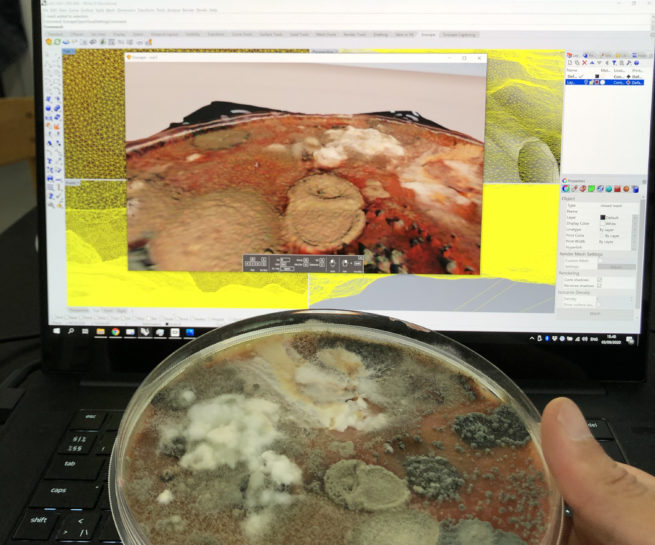

Digital Materialities was an artistic research project committed to investigating the many ways in which our everyday life entangles with digital and biological networks. The project was initiated by visual artists Malene Bang, Oskar Koliander, and Karen Harsbo along with theorist and educator Maibritt Borgen. Initiated in spring of 2020, the project unfolded as a 4-year collaboration across laboratories at the Royal Danish Academy of Art, Schools of Visual Arts